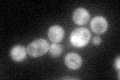
YPL086C
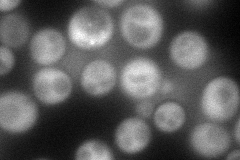
YPL086C
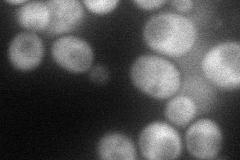
YPL086C
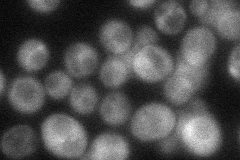
YPL086C
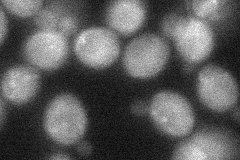
YPL086C
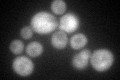
YPL086C
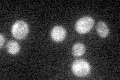
YPL086C

View description
Subunit of Elongator complex, which is required for modification of wobble nucleosides in tRNA; exhibits histone acetyltransferase activity that is directed to histones H3 and H4; disruption confers resistance to K. lactis zymotoxin
Localization:
Intensity:
Fold change:
Significance:
-
C’ GFP library in SD
cytosol55.75 -
N' NOP1pr-GFP in SD
cytosol,punctate97.4896 -
N' TEF2pr-mCherry in SD
punctate62.289 -
N' NATIVEpr-GFP in SD
cytosol46.7574 -
N' TEF2pr-VC and Cyto-VN in SD
cytosol36.9097 -
C’ GFP library in SD+DTT
cytosol41.010.73No -
C’ GFP library in SD+H2O2

cytosol57.831.03No -
C’ GFP library in Starvation Media
cytosol27.10.48No -
C’ GFP library on the background of Pup2-DaMP

cytosol -
C’ GFP library on the background of CCT mutant

cytosol52.81240.947126No
